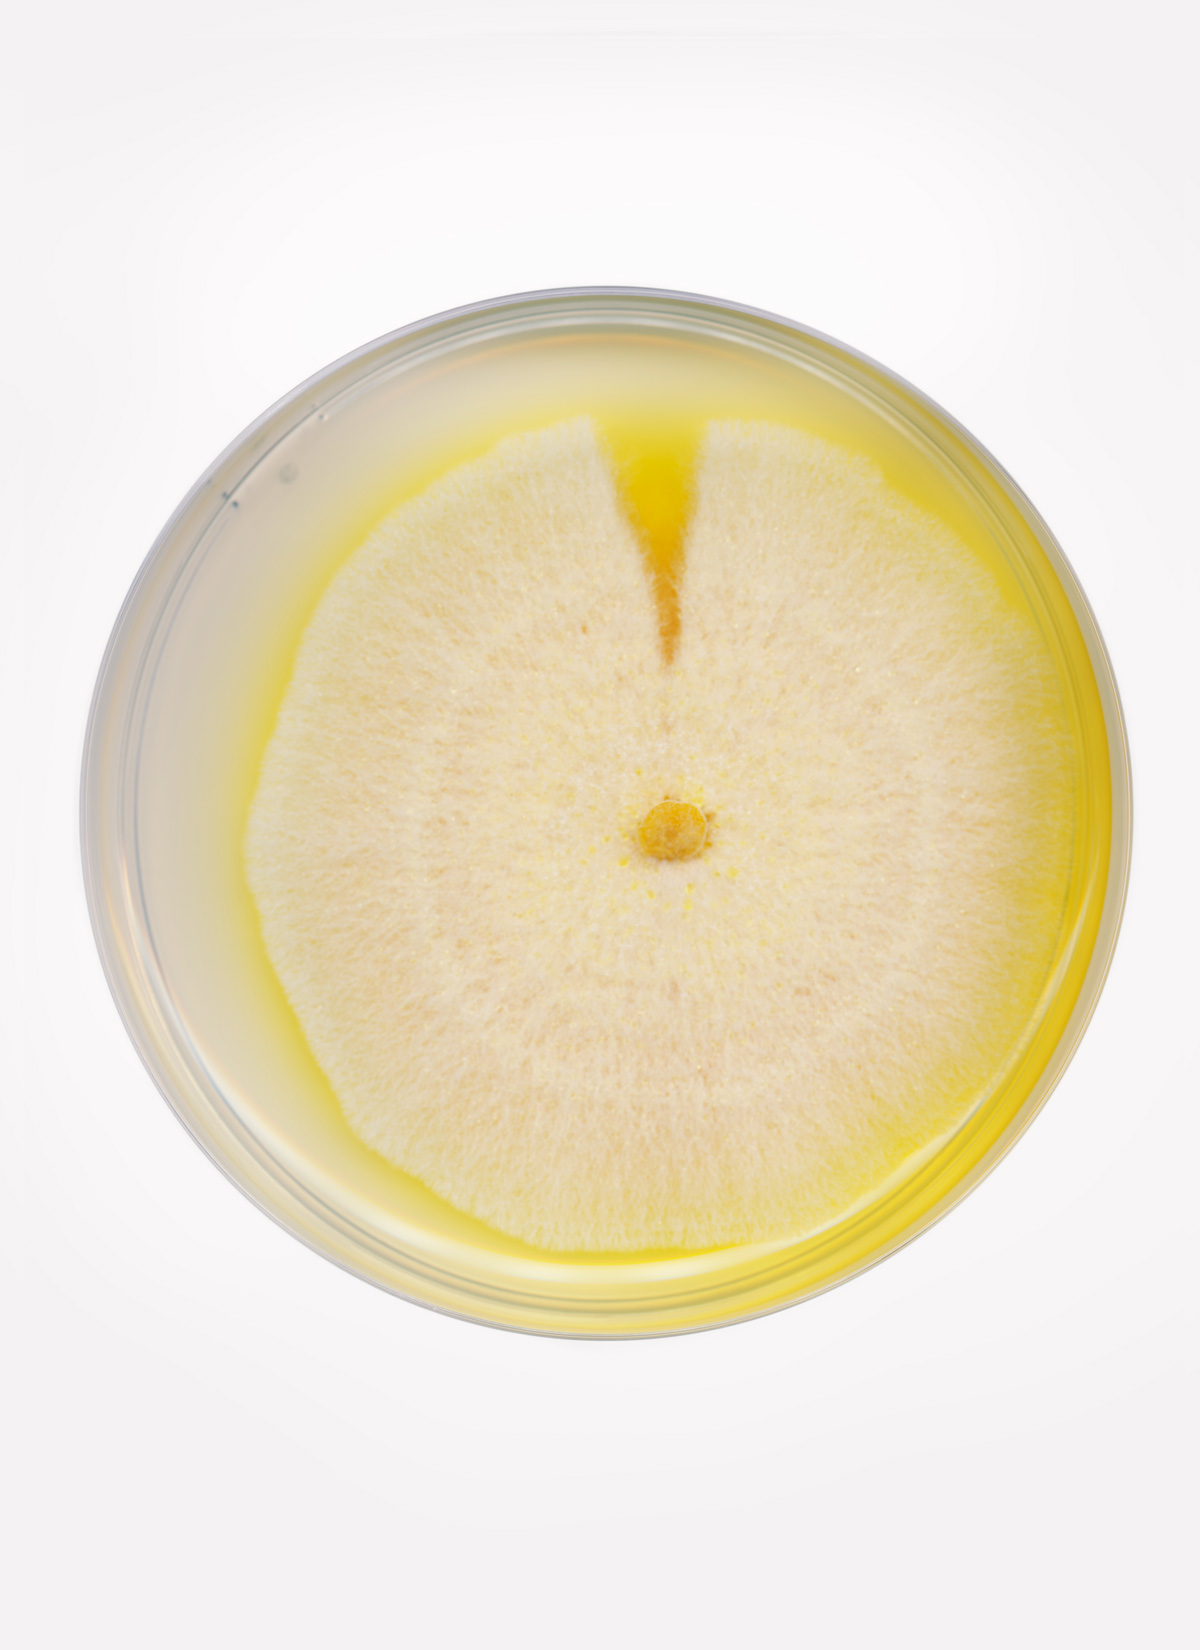
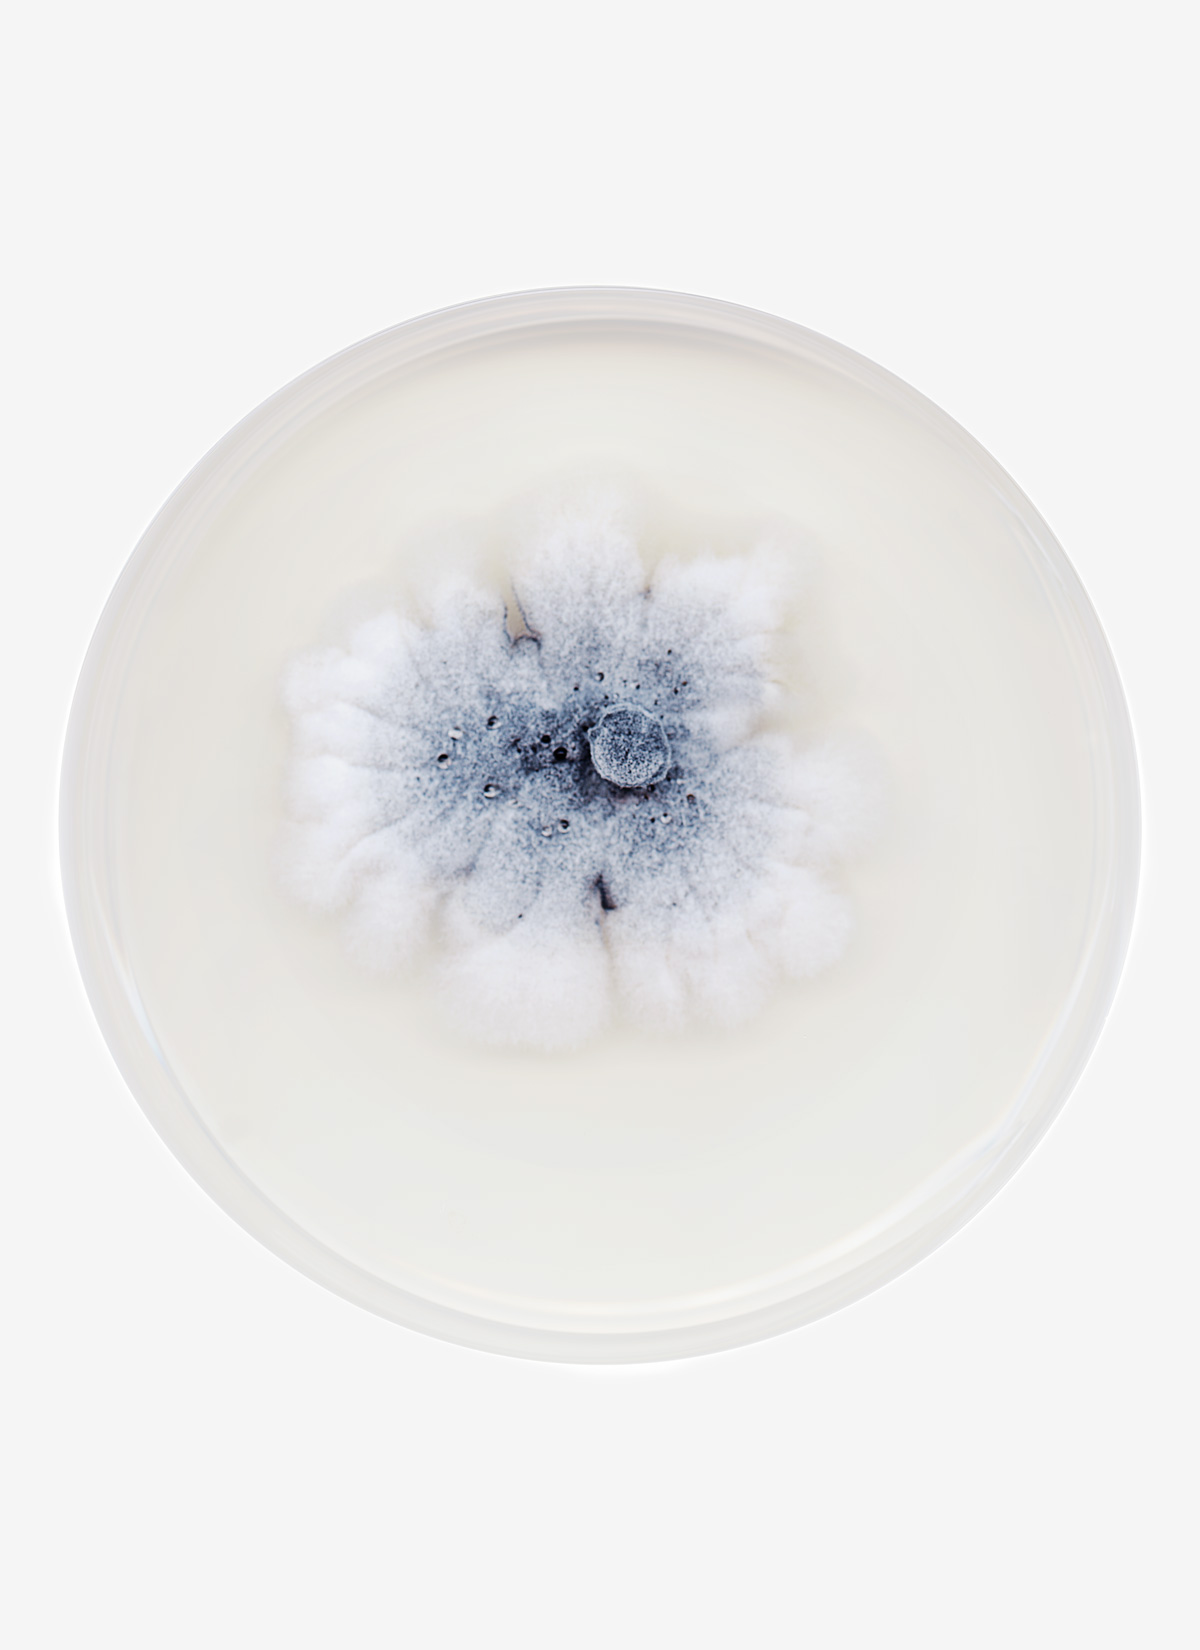

Maria Lund
→ y aller7.11.2025 – 10.1.2026
jeudi 6.11 17h-20h30 vernissage en présence de l'artiste
ven 7.11 18h-19h30 signature du livre Fungi
sam 8.11 17h talk avec Clémentine Mercier
Nicolai HOWALT
F.U.N.G.I.
Le photographe plasticien danois Nicolai Howalt pratique ce que l’on pourrait appeler une mise en lumière. Explorateur de l’incompréhensible, des aspects de la vie humaine qui nous échappent par leur échelle ou leur invisibilité, l’artiste adopte une démarche expérimentale et sérielle pour saisir, rendre visible ou simplement exposer les questions que soulèvent son sujet. Méthode et aléatoire se rencontrent ; le positionnement de Nicolai Howalt est humble, empreinte de doute. Il n’impose rien mais nous montre un monde où l’être humain apparaît minuscule face à la nature et une temporalité qui le dépasse. Son travail s’accompagne fréquemment d’échanges avec des scientifiques, matérialisés par des textes publiés dans ses livres.
À une époque où la photographie est omniprésente Nicolai Howalt en explore et en défie les fondements. Il combine techniques analogiques, processus et technologies biologiques avec des médiums et matériaux nouveaux. Il crée ainsi des œuvres qui mettent en avant l’imprévisibilité de la matière, dialogue avec notre réalité commune et examinent les liens entre photographie, temps et transformation. Sa pratique prend souvent la forme d’un échange avec les matériaux, qui ne servent pas uniquement d’outils mais agissent en tant que cocréateurs des œuvres.
Avec F.U.N.G.I. Nicolai Howalt explore le monde vital des champignons et des mycéliums, un monde habituellement invisible à l’œil nu mais tout aussi important à la vie sur terre que l’oxygène ou la lumière du soleil. Dans ses œuvres, les champignons influencent directement le processus créatif. L’artiste crée des photogrammes organiques en cultivant une sélection de spores de champignons directement sur du papier analogique, photosensible, qu’il développe ensuite à la chambre noire. La dégradation du papier par les champignons donne naissance à des motifs abstraits, quasi cosmiques. Les photos de spores cultivées dans des boites de Pétri révèlent une diversité multicolore de croissances sphériques, que l’artiste a imprimé recto-verso sur verre, de façon à exposer la vision du dessus et d’en-dessous de chaque boite. Ces œuvres sont présentées perpendiculairement au mur. Une troisième série résulte de l’utilisation comme négatif de champignons cultivés en couches très fines et séchés.
Nicolai HOWALT

SIGNATURE
vendredi 7.11
18h-19h30
18h-19h30
Nicolai Howalt signe son livre Fungi (éd. Fabrikbooks, 2025) publié à l’occasion de l’exposition.
TALK
samedi 8.11
17h
17h
Nicolai Howalt en conversation avec Clémentine Mercier, critique d’art et Prix AICA 2024
Galerie Maria Lund
www.marialund.com
instagram @galeriemarialund
01 42 76 00 33
galerie@marialund.com
48 rue de Turenne · Paris 3e
mardi-samedi 12h-19h / et sur rdv
accès libre
